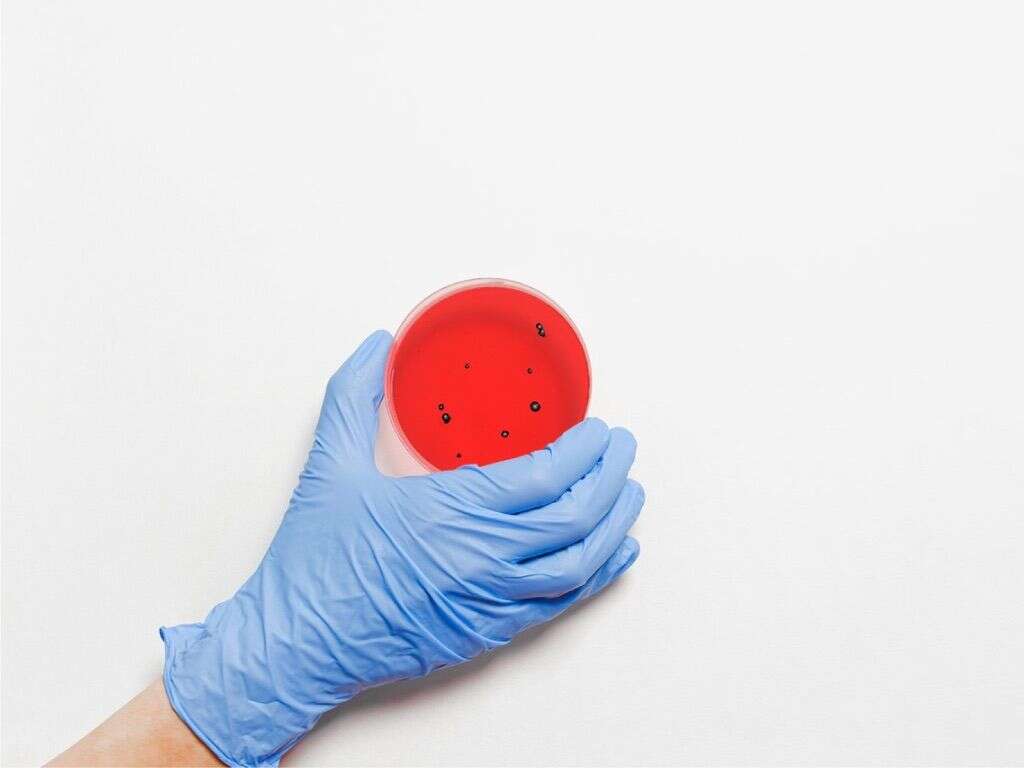

10 Papilledema Symptoms
Advertisement Papilledema is a condition affecting the optic nerve behind the eye. Increased intracranial pressure...
28 May, 2023
Advertisement Papilledema is a condition affecting the optic nerve behind the eye. Increased intracranial pressure...
28 May, 2023
Advertisement Typically, the eyes produce tears, mucus and oils that keep them healthy and help...
20 Feb, 2023
Advertisement Corneal ulcers or corneal abrasions, are open sores in the cornea of the eye....
19 Oct, 2022
Advertisement For those wondering what those crusty formations on their eyelids are, the colloquial term...
04 Aug, 2022
Advertisement Although normally harmless, eyelid bumps are sometimes painful or uncomfortable. They can also affect...
14 Jan, 2022
Advertisement Composed of loose, stretchy skin less than 1 millimeter thick, eyelids protect the eyes...
03 Nov, 2021
Advertisement Blurry vision is a common issue in which a person is unable to see...
28 May, 2021
Advertisement Pink eye, or conjunctivitis, results from inflammation of the conjunctiva of the eye, which...
18 Mar, 2021
Advertisement Your brain receives information on what the eyes see through the optic nerve, which...
06 Mar, 2021
Advertisement When viruses, bacteria, fungi, or parasites invade the eyes or surrounding areas, the result...
27 Jan, 2021
Advertisement When it first occurs, it can be mildly disconcerting or even frightening. Patterns of...
26 Dec, 2020
Advertisement At the back of our eyes internally is a thin membrane known as the...
22 Dec, 2020
Advertisement Conjunctivitis, commonly known as pink eye, is an inflammation of the surface of the...
24 Nov, 2020
Advertisement You are probably familiar with the cornea, retina, pupil and lens of the eye....
31 Oct, 2020
Advertisement The eyes are very sensitive parts of the body, and it’s easy for the...
27 Oct, 2020
Advertisement It is common for us to experience issues with our eyesight as we get...
21 Oct, 2020
Advertisement Life would be very different for us if we were to lose our vision....
26 Aug, 2020
Advertisement The eye is one of the most fantastic features of most animal life on...
18 Aug, 2020
Advertisement At the very front of the eye is a clear protective layer known as...
14 Jun, 2020
Advertisement Our eyes are protected by thin flaps of skin that are known as eyelids....
07 May, 2020
Advertisement Red eyes may occur when there is irritation or inflammation of the eyes. It...
18 Apr, 2020
Advertisement Conjunctivitis, pink eye, or red eye occurs when there is inflammation of the conjunctiva....
17 Apr, 2020
Advertisement Papilledema, also called papilledema, is a condition that affects the optic disc of the...
01 Apr, 2020
Advertisement A stye or sty, is an infection that affects the eyelid causing a small...
30 Mar, 2020
Advertisement Astigmatism is a condition that occurs as a result of an error in the...
29 Mar, 2020
Advertisement Pinkeye, otherwise called conjunctivitis, is a condition in which the outer lining of the...
28 Mar, 2020
Advertisement Glaucoma is an eye condition that causes damage to the optic nerve. The condition...
27 Feb, 2020
Advertisement Eye cancer is rare. It may affect the outer areas of the eye, which...
27 Jan, 2020
Advertisement The uvea refers to the pigmented part of the three concentric layers of the...
14 Dec, 2019
Advertisement Infections come in a variety of types. They can be caused by bacteria, viruses,...
20 Nov, 2019
Advertisement Light enters into our eyes and is focused onto the retina at the back...
11 Sep, 2019
Advertisement The conjunctiva is a thin, transparent membrane that helps provide protection for the front...
04 Sep, 2019
Advertisement Strabismus is the medical term that describes a condition more commonly referred to as...
06 Aug, 2019
Advertisement Pink eye is a term used to describe the appearance of eyes affected by...
03 Aug, 2019
Advertisement Itchy eyes can be very irritating indeed. It can be almost impossible to stop...
23 Jul, 2019
Advertisement Double vision, also known as diplopia, can be defined as the concurrent perception of...
16 Jul, 2019
Advertisement A chalazion is a bump that can be found on the eyelids. Whereas a...
11 Jul, 2019
Advertisement Eye infections can be quite nasty. They can be itchy, sore, and painful and...
07 Jul, 2019
Advertisement Many of us have eye floaters. They are specks in your vision that just...
07 Jul, 2019
Advertisement If you’ve had a migraine in the past, and many people have, you will...
05 Jul, 2019
Advertisement Adenoviruses are common viruses that can cause a variety of issues such as cold-like...
17 Jun, 2019
Advertisement Blurry vision refers to vision where there may be fuzzy or hazy lines instead...
04 Feb, 2019
Advertisement Could you imagine having to be without your eyes? While many people are blind...
20 Jan, 2019
Advertisement Nystagmus is a condition where there is involuntary eye movement that is acquired resulting...
10 Nov, 2018
Advertisement Eye styes are issues that are usually caused by bacteria, oftentimes bacteria that naturally...
05 Nov, 2018
Advertisement A swollen eyelid occurs when there is an inflammation of the connective tissue that...
31 Oct, 2018
Advertisement Blepharitis is a condition characterized by sore, red, and crusty eyelashes caused by an...
25 Oct, 2018
Advertisement Astigmatism is a condition that causes blurry or distorted vision in the eyes. It...
24 Oct, 2018
Advertisement Retinal detachment is a serious vision problem that requires emergency attention. If not addressed...
23 Oct, 2018
Advertisement The term glaucoma refers to a group of eye diseases that lead to the...
18 Oct, 2018
Advertisement Optic neuritis is a condition where there is inflammation and demyelination of the optic...
15 Oct, 2018
Advertisement The retina is the light-sensitive layer at the back of the eye that contains...
13 Oct, 2018
Advertisement A stye, also called hordeolum is a pimple-like bump that usually occurs on the...
17 Jul, 2018
Advertisement Pink eye or conjunctivitis is the inflammation of the conjunctiva, a layer of tissue...
06 Jul, 2018
Advertisement Eye twitching is common and typically benign, meaning not a serious medical condition. It...
05 Apr, 2018Home | Privacy Policy | Editorial | Unsubscribe | About Us
This site offers information designed for entertainment & educational purposes only. With any health related topic discussed on this site you should not rely on any information on this site as a substitute for professional medical diagnosis, treatment, advice, or as a substitute for, professional counseling care, advice, treatment, or diagnosis. If you have any questions or concerns about your health, you should always consult with a physician or other health-care professional.